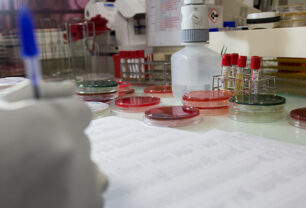

Context
A year after the Maputo Declaration, which highlighted the importance of laboratories in health systems in 2008, the West African Network of Biomedical Analysis Laboratories (RESAOLAB) was the first regional-scale project to emerge with the aim of responding to the lack of multilateral aid and government investment in the field of diagnostics.
Designed with West African health stakeholders and the ministries of health in the member countries, the network takes into account all factors affecting the governance and performance of laboratories.
RESAOLAB unites the laboratory departments (LDs) responsible for laboratories within ministries of health in West Africa. Each LD defines the country’s vision and strategy for laboratory development, structures and leads the national laboratory network, and coordinates support for strengthening laboratory systems.
Objectives
RESAOLAB aims to strengthen laboratory systems in West Africa to improve the quality of biomedical services. The project promotes a regional approach among member countries to support the implementation of national policies and strengthen laboratory systems for the long term.
Activities
Managed in close collaboration with the health ministries of seven countries, and more specifically with the departments responsible for laboratories, RESAOLAB develops a framework for discussion and support for the implementation of capacity-building activities in four areas:
- Strengthening the governance of laboratory systems and the implementation of national strategies
- Developing and supporting training to strengthen the skills of laboratory staff
- Improving quality management in laboratories
- Supporting laboratory-based surveillance with data management systems
All members of the network meet annually at themed workshops to discuss the activities carried out and share the results obtained in response to the challenges of the laboratory sector.
An operational unit within each ministry is responsible for implementing activities under the supervision of a national steering committee and an international steering committee, which meets once a year.
Three-phase support
Founded in 2009, the RESAOLAB network was born from a shared vision of regional collaboration supporting the smooth operation of laboratory services to improve population health through the prevention and early diagnosis of diseases.
The network was initiated by the Mérieux Foundation in 2009 in collaboration with Burkina Faso, Mali, and Senegal. Four more countries joined in 2013: Benin, Guinea, Niger, and Togo.
The network’s activities took shape through three project phases, the last of which began in 2019 under a partnership between the Mérieux Foundation and the French Development Agency (AFD), with a view to continuing to strengthen the laboratory systems.
Phase 1 of RESAOLAB: 2009-2013
RESAOLAB was initiated by the Mérieux Foundation in 2009 with support from the French Development Agency, at the request of the health ministries in Burkina Faso, Mali, and Senegal.
It was the first program dedicated to laboratories in West Africa following the WHO Maputo Declaration, which addressed the need to strengthen laboratories.
Phase 2 of RESAOLAB: 2013-2017
The second phase of the project gained momentum as the network expanded to include four new West African countries: Benin, Guinea, Niger, and Togo.
In addition to the AFD and the Mérieux Foundation, this phase of the project was also supported by the Monaco Department of International Cooperation, the Stavros Niarchos Foundation, and the Islamic Development Bank.
Key achievements of phases 1 and 2:
Phases 1 and 2 of RESAOLAB enabled:
Stronger governance of laboratory systems:
- Seven countries developed policies and strategic plans for the development of laboratory systems
- Networking between the seven departments responsible for laboratories
- Four LD buildings constructed
Development and support for laboratory staff training:
- Support for the establishment of regional continuing training in laboratory equipment maintenance
- Development of training modules to enhance the skills of laboratory staff
- Thirty-six DES (diploma of specialized studies) grants for Medical Biology awarded
Improvements to quality in laboratories:
- A regional program for external quality assessment in hematology and biochemistry defined and implemented
Support for laboratory-based surveillance:
- A system developed to support laboratory data management and epidemiological surveillance
Twenty workshops have been organized, bringing together medical biology experts from West Africa to share their experience and knowledge.
Phase 3 of RESAOLAB: 2019-2026
The third phase of the project was launched in September 2019. Building on the previous phases, it aims to support the implementation of strategies to develop laboratory systems and ensure the sustainability of the network.
The goal of this phase is to further strengthen institutions and support the implementation of national medical biology policies, as well as building technical capacity for biological diagnostics. It is helping to maintain regional momentum towards the harmonization of medical biology.
Specific provision for COVID-19
To enable countries to fight the epidemic, the AFD allocated an additional grant of €1.5 million to the project as part of the “COVID-19 – Health in Common” initiative. This funding enabled the development of laboratory-based COVID-19 response strategies, mobilizing the network’s expertise to support national responses.
This specific support contributed to the adaptation and strengthening of technical facilities, the decentralization of diagnostic capacity, and the sharing of experience and knowledge.
In addition to this specific assistance, network members stressed that RESAOLAB’s advocacy and long-term support for the establishment of bodies dedicated to laboratory issues bolstered their involvement in managing the response to the disease.
Expected results
The expected results of phase 3 of the project in each area of intervention are as follows:
Stronger governance:
- Laboratory Departments are able to monitor and regulate laboratory systems.
Development and support for training:
- The critical mass of biologists is growing,
- The abilities of laboratory staff are up to date
Quality management:
- Practices are harmonized and strengthened in accordance with international standards
Surveillance support:
- Laboratory-based surveillance is operational in the countries in the network
Regional momentum for ensuring that laboratory systems are operational and harmonized in West Africa
Key success factors and future challenges*
- The targeted focus on advocacy activities and strengthening the governance of laboratory systems by creating dedicated entities has been identified as the most decisive factor in successfully achieving results and ensuring the sustainability of the support provided by the project. This focus has enabled the creation of the laboratory departments, given them visibility and recognition, and enabled them to fulfill their advocacy role on behalf of the medical biology sector.
- Thanks to its close proximity to network members, the “bottom-up” approach has been recognized as rendering the support more flexible and better able to integrate requirements into the implementation of national policies.
- The sustainability of the technical (Mérieux Foundation) and financial (AFD) partnership has also been identified as a major factor in the project’s success.
- Thanks to the visibility and recognition given to laboratory management, other approaches and direct support for national priorities have been mobilized to complement the assistance provided by RESAOLAB (Global Fund, Global Health Security Agenda/USAID, REDISSE/World Bank).
- The momentum created by the network is a key factor in exchanges between peers, the pooling of activities, and the harmonization of practices at the regional level.
As phase 3 of the project draws to a close, challenges have been identified at two levels.
Firstly, at the national level, inter-donor coordination and the development of action plans adapted to the absorption capacities of partners have been identified as a major challenge. While training has been a major focus of action, the operationalization of post-training skills needs to be strengthened.
Meanwhile, initiatives in phase 3 at the network level to ensure its sustainability outside the project framework must be continued and strengthened to ensure it gradually achieves autonomy. A particular need has been identified to maintain regional momentum for the benefit of national priorities.
*Based on the results of the mid-term project review commissioned by the AFD.
Learn more about RESAOLAB